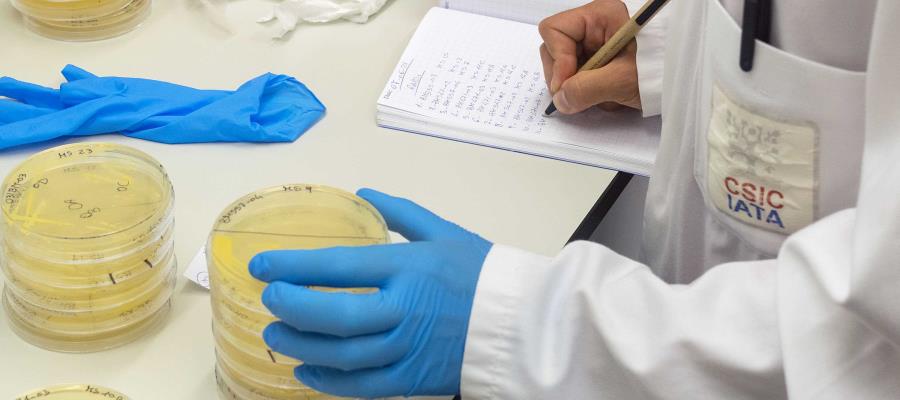
Existen anticuerpos contra COVID-19 en leche materna de vacunadas, revela estudio en España Existen anticuerpos contra COVID-19 en leche materna de vacunadas, revela estudio en España

Existen anticuerpos contra COVID-19 en leche materna de vacunadas, revela estudio en España
Un estudio realizado por investigadoras del Instituto de Agroquímica y Tecnología de Alimentos (IATA) así como del Servicio de Pediatría del Hospital Clínico de Valencia, España, descubrieron que la leche materna de mujeres que se infectaron de SARS-CoV-2 y vacunadas contiene anticuerpos contra la enfermedad.
Revelaron que el tipo de anticuerpos encontrados en las muestras fue específico y que los resultados variaron según el tipo de vacuna que recibieron, además detallaron que el número de anticuerpos incrementó en mujeres que tenían entre una y dos dosis aplicadas.
Las mujeres que estuvieron infectadas presentaron niveles de anticuerpos equivalentes a los de las mujeres sanas que recibieron la vacuna completa. La científica María Carmen Collado, dijo que se deberá investigar si los anticuerpos son realmente neutralizadores del virus.
“Nuestros resultados muestran que en ninguna leche materna fuimos capaces de detectar el RNA del virus y encontramos que en la mayoría de las mujeres infectadas había presencia de anticuerpos, sugiriendo que la leche materna es un vehículo de transmisión de anticuerpos, sin embargo, todavía necesitamos estudiar más, identificar si esos anticuerpos son realmente neutralizadores y protectores en el niño. Hemos visto que hay una gran variabilidad entre mujeres en función de las diferentes vacunas. Hemos visto que además la presencia de anticuerpos también difiere entre vacunas y lo más interesante es que entre mujeres que ya han pasado la COVID cuando reciben la primera vacunación presentan anticuerpos elevados en niveles muchos más altos que las segundas vacunaciones, sugiriendo como se está de acuerdo en la literatura que una única dosis de vacuna en personas que han pasado la COVID, sería suficiente”, agregó.
Short Link: https://is.gd/1rXET5
Comentarios